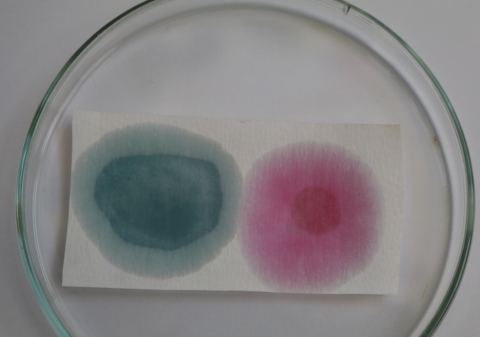

Разноцветный сок из капусты

Для сегодняшнего эксперимента нам понадобится краснокочанная капуста, вернее сок из нее. Я выжму сок с помощью соковыжималки, так быстрее и соку получится много (соковыжималка зверь, жмет почти до суха). Это можно сделать и вручную: предварительно натереть капусту на терку или пропустить через мясорубку, а затем отжать сок в марле.
Из головки среднего размера у меня вышло около 400 мл сока.
Их жмыха можно приготовить отвар, он тоже будет окрашенный и его можно использовать для опытов. Кстати, для подобных опытов часто рекомендуют именно отвар. Но получить такую интенсивную окраску как из сока с него не получится.
Сок из соковыжималки содержит пену и небольшое количество мякоти, потому его нужно профильтровать, например, через металлическое ситечко для чая.
В баночке слева - профильтрованный.
Для эксперимента, кроме капустного сока, нам понадобится кислота и щелочь.
В качестве кислоты можно использовать столовый уксус, (яблочный, винный или любой другой уксус), растворенную в воде лимонную кислоту, лимонный сок и т.п. Главное, чтоб используемый Вами кислотный раствор был прозрачный и не имел собственной интенсивной окраски.
В качестве щелочи подойдет раствор соды, аптечные капли нашатыря, раствор мыла.
Я буду использовать столовый уксус и раствор пищевой соды. Чайную ложку соды растворяем в полстакана воды, хорошо размешиваем, ждем пару минут и сливаем осветленную часть раствора без осадка.

Посуду можно использовать любую, какая есть в доме. Я использую химическую, потому что она у меня есть: два стаканчика, две колбочки на 100 мл, стеклянная палочка, чашка Петри.
Из «особенных» вещей, которые следует заготовить заранее – пипетки и фильтровальная бумага. Бумагу можно использовать любую, что-то на подобие советской промокашки, но качество эксперимента будет немного не то. Я бы советовала Вам купить настоящую фильтровальную бумагу, так как в дальнейших опытах мы еще будем ею пользоваться.
Это же касается пластиковых пипеток. Их можно заменить другими, например стеклянными из аптеки, но те, которыми пользуюсь я, будут более удобными для ребенка.
Фильтровальная бумага в листах. Из нее можно вырезать кусок нужной формы.
Пипетки полиэтиленовые с градуировочной шкалой на 3 мл.

Где купить реактивы и расходные материалы, я буду писать в отдельной теме по ссылке (добавлю), чтобы не повторятся каждый раз.
Наливаем капустный сок в прозрачные стаканчики. Примерно по 20-25 мл. Необходимо оставить в посуде свободное место, зачем, увидите позже.
Сок из капусты имеет насыщенный фиолетовый цвет.
А теперь посмотрим как изменится окраска сока после добавления в него кислоты и щелочи.
Добавили кислоту - окраска начала смещаться в красную сторону. Это видно с каждой каплей, чем больше кислоты, тем больше сок становится розово-красным.
Во второй стаканчик добавляем по капле пипеткой щелочь. Окраска сока становится голубой, а затем зеленеет.
Вот что мы получили.
Пару капель наносим на фильтровальную бумагу, чтоб лучше был виден полученный цвет.
Капли постепенно расползаются по бумаге и, в конечном итоге, смыкаются.
Обратите внимание, на стыке образуется зона с голубой окраской. Здесь при встрече капель кислота нейтрализует щелочь и окраска сока изменяется.
А теперь сольем сок из двух стаканчиков в один.
Лить нужно медленно, потому что будет обильное пеновыделение.
При смешение кислотного и щелочного раствора проходит реакция нейтрализации. При этом щелочь и кислота "уничтожают" друг друга, превращаясь в воду. При этом выделяется углекислый газ, который и вспенивает сок.
Для особо любознательных отмечу, что углекислый газ выделяется при смешение кислоты и щелочи не всегда, в данном случае он есть, потому что мы используем соду (Na2CO3). Если бы мы использовали раствор мыла, то газоотделения бы не было.
Обратите внимание какая яркая и многоцветная образуется пена.
Пены образуется много, если бы мы использовали большее количество раствора, то она вы "убежала" за пределы стакана.
Получаем стакан разноцветного коктейля)
Окраска пены постепенно тускнеет и становится однородной по цвету - розово-фиолетовой.
Цвет сока возвращается в свой исходный цвет. Нейтрализация прошла полностью. Кислота и щелочь в нем исчезла. Когда пена осядет, жидкость можно слить и использовать ее для экспериментов повторно - добавлять кислоту, щелочь, сок опять будет менять цвет.
Проведем еще один небольшой эксперимент, который позволит наблюдать описанные выше цветовые переходы как бы в замедленной съемке.
Полоску фильтровальной бумаги хорошо увлажним соком.
Затем капнем на противоположные концы полоски по капле наших растворов.
Слева щелочь:
А справа кислоту.
Будем наблюдать как движется цветной фронт. В какой то момент, пока движется фронт капли, четко видны все оттенки цветного перехода от красного до зеленого: розовый, фиолетовый голубой.
Затем два фронта соединяются и бумажка становится двухцветной: розово-зеленой, с небольшой переходной зоной зелено-голубого оттенка.
Для сравнения покажу фильтровальную бумагу, которую мы использовали с Вами в этом опыте раньше. Видите, она высохла и стала ярко-зеленой.
О том, что можно делать интересного с такой бумагой, мы поговорим в следующей теме)

Комментарии
Вот это фокусы...у нас есть всё...даже такая же соковижималка....только бумаги этой заковыристой нет....будем ждать ссылку что где купить )))
Соня - факир !!! )))
например тут https://agrohimlaborant.prom.ua/p387255189-bumaga-filtrovalnaya-laboratornaya.html
есть много предложений в гугле. листами и в пачках.
можно и такую круглую, но она дороже и нет смысла ее брать
пипетки, например, здесь https://silur.prom.ua/p17985839-pipetka-pastera-plastikovaya.html
я потом все напишу в отдельной теме.
Сонь, там где ты начинаешь работать с соком (наливаешь в стеклянную градуированную посуду) ты написала 5 мл сока...)))) может 35? или 50? ))) у меня тоже бывает кнопки заедают...Сейчас приступаем к твоим фокусам
Лена, да, таки заело)))) Должно быть не 5 мл, а 25 мл. Купила новую клавиатуру, надеюсь скоро буду с "буквами и цифрами".
Исправила, спасибо